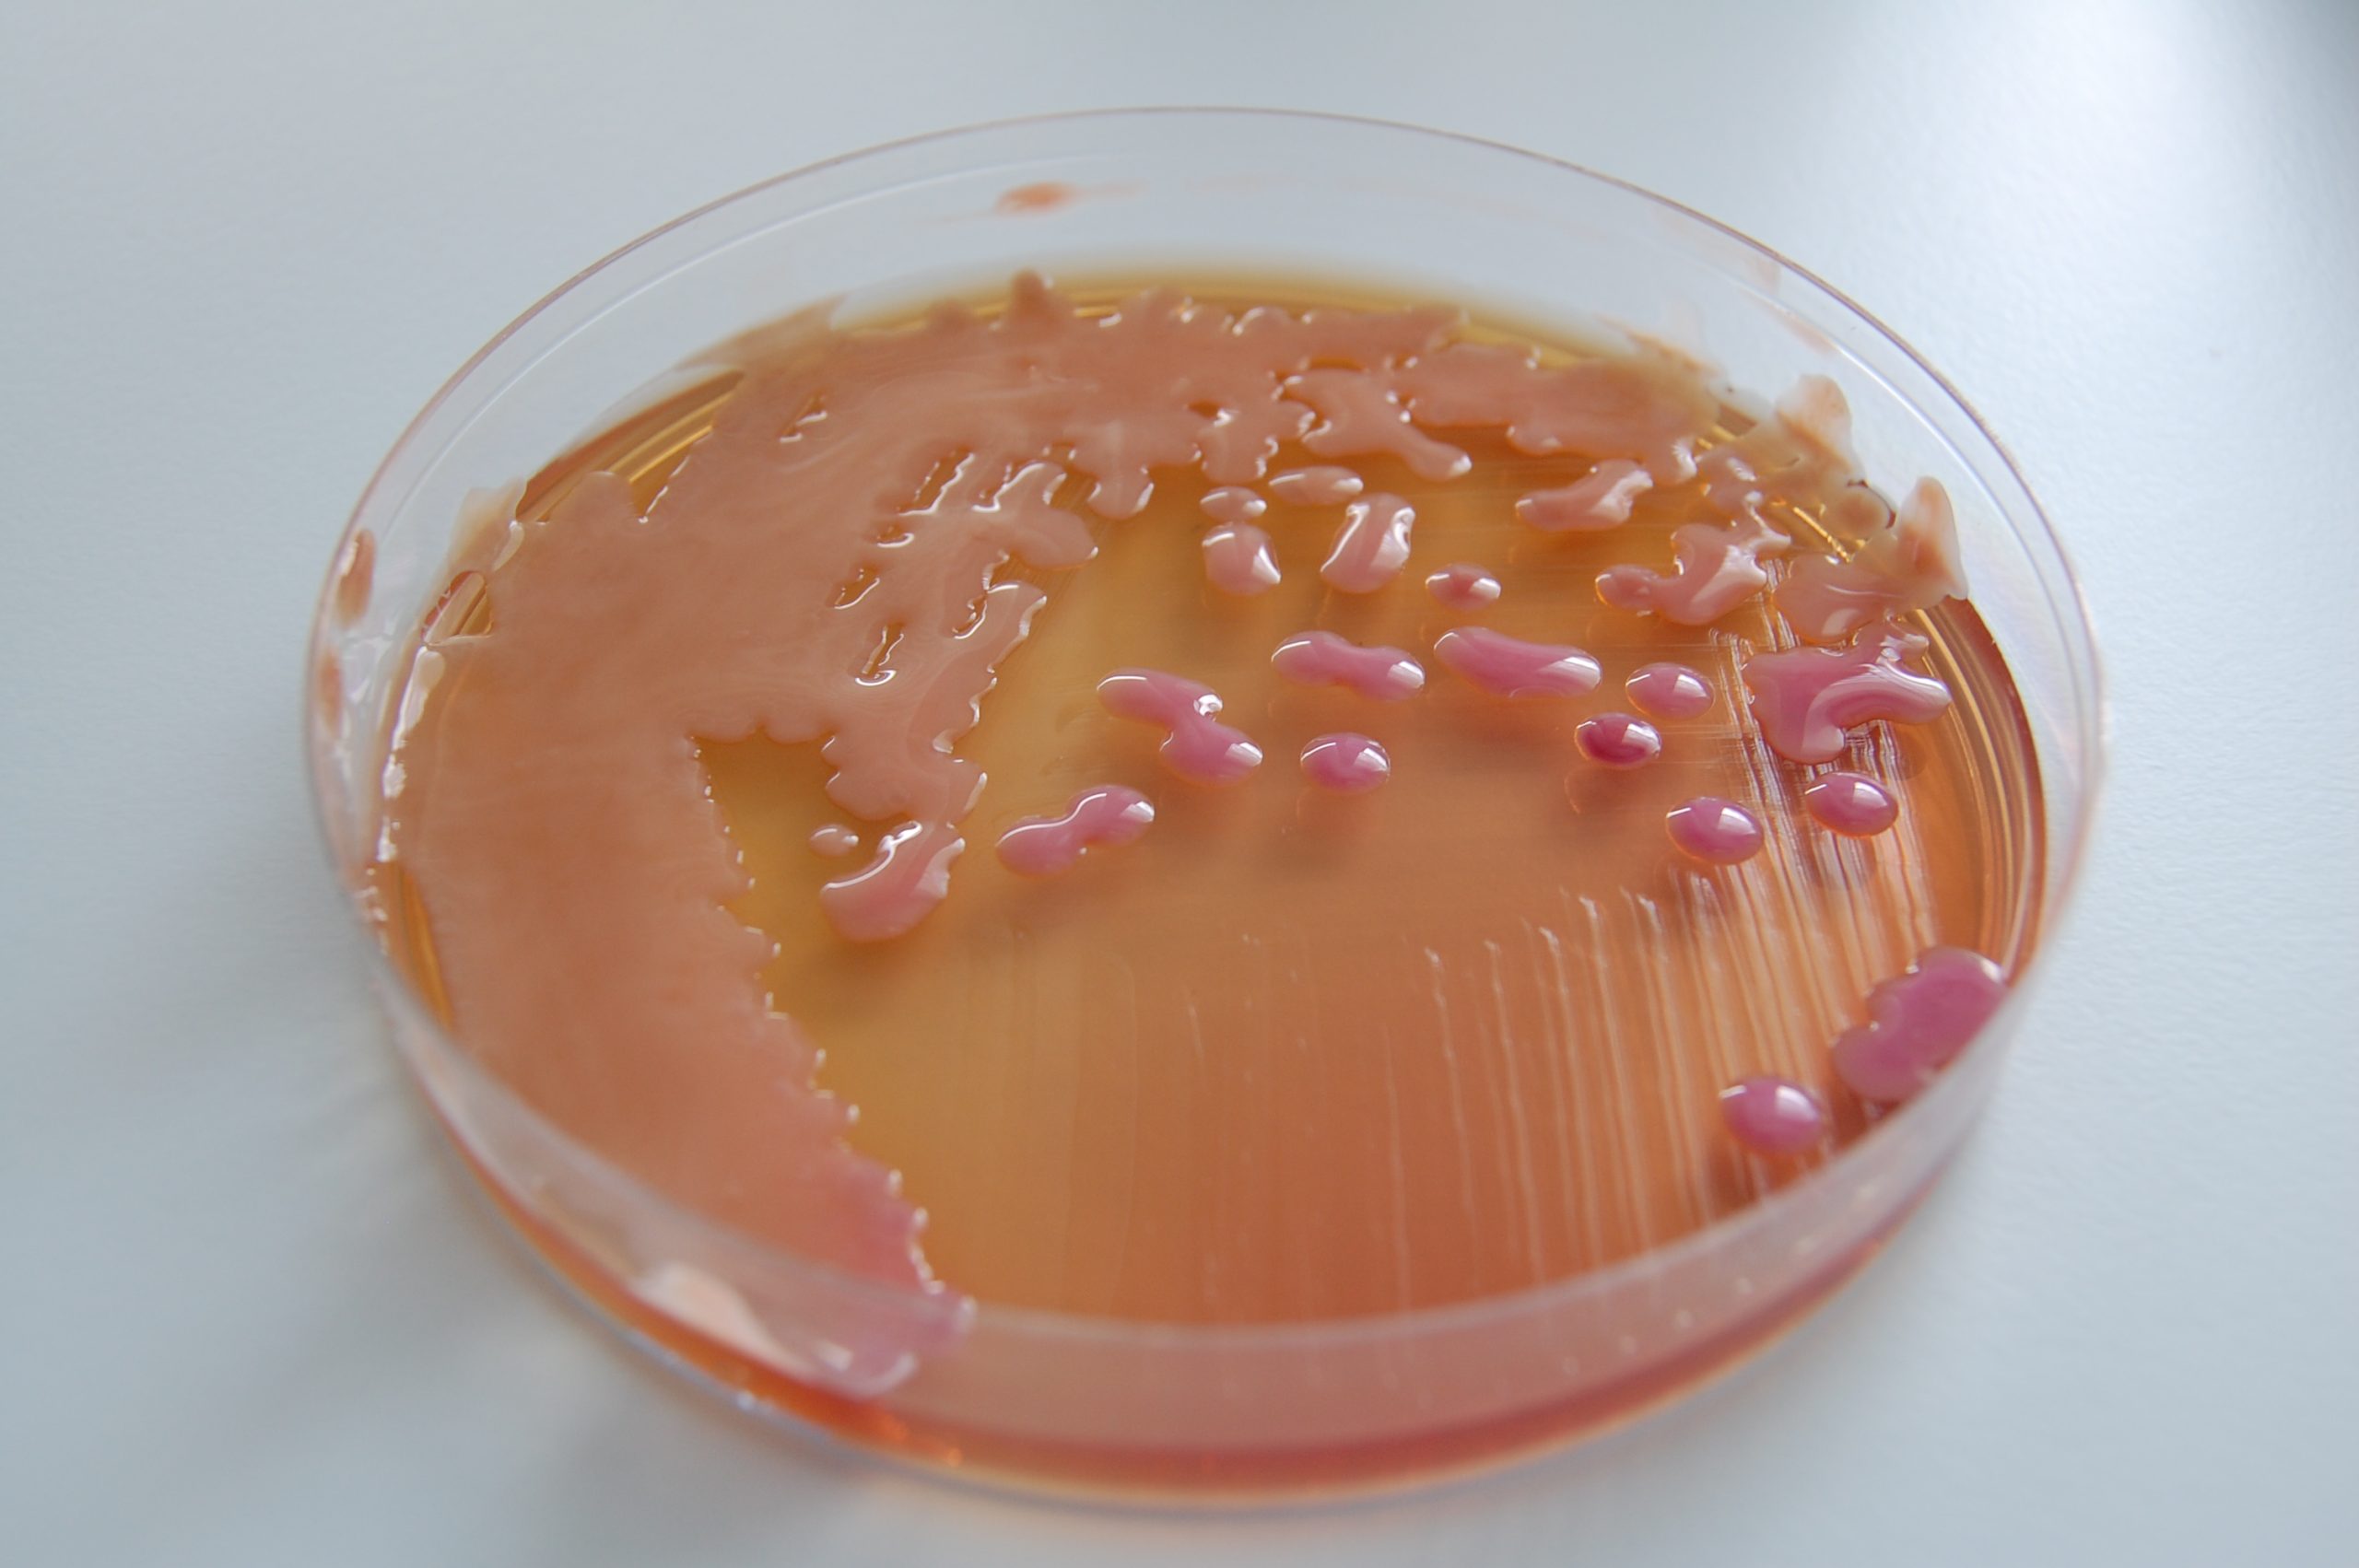
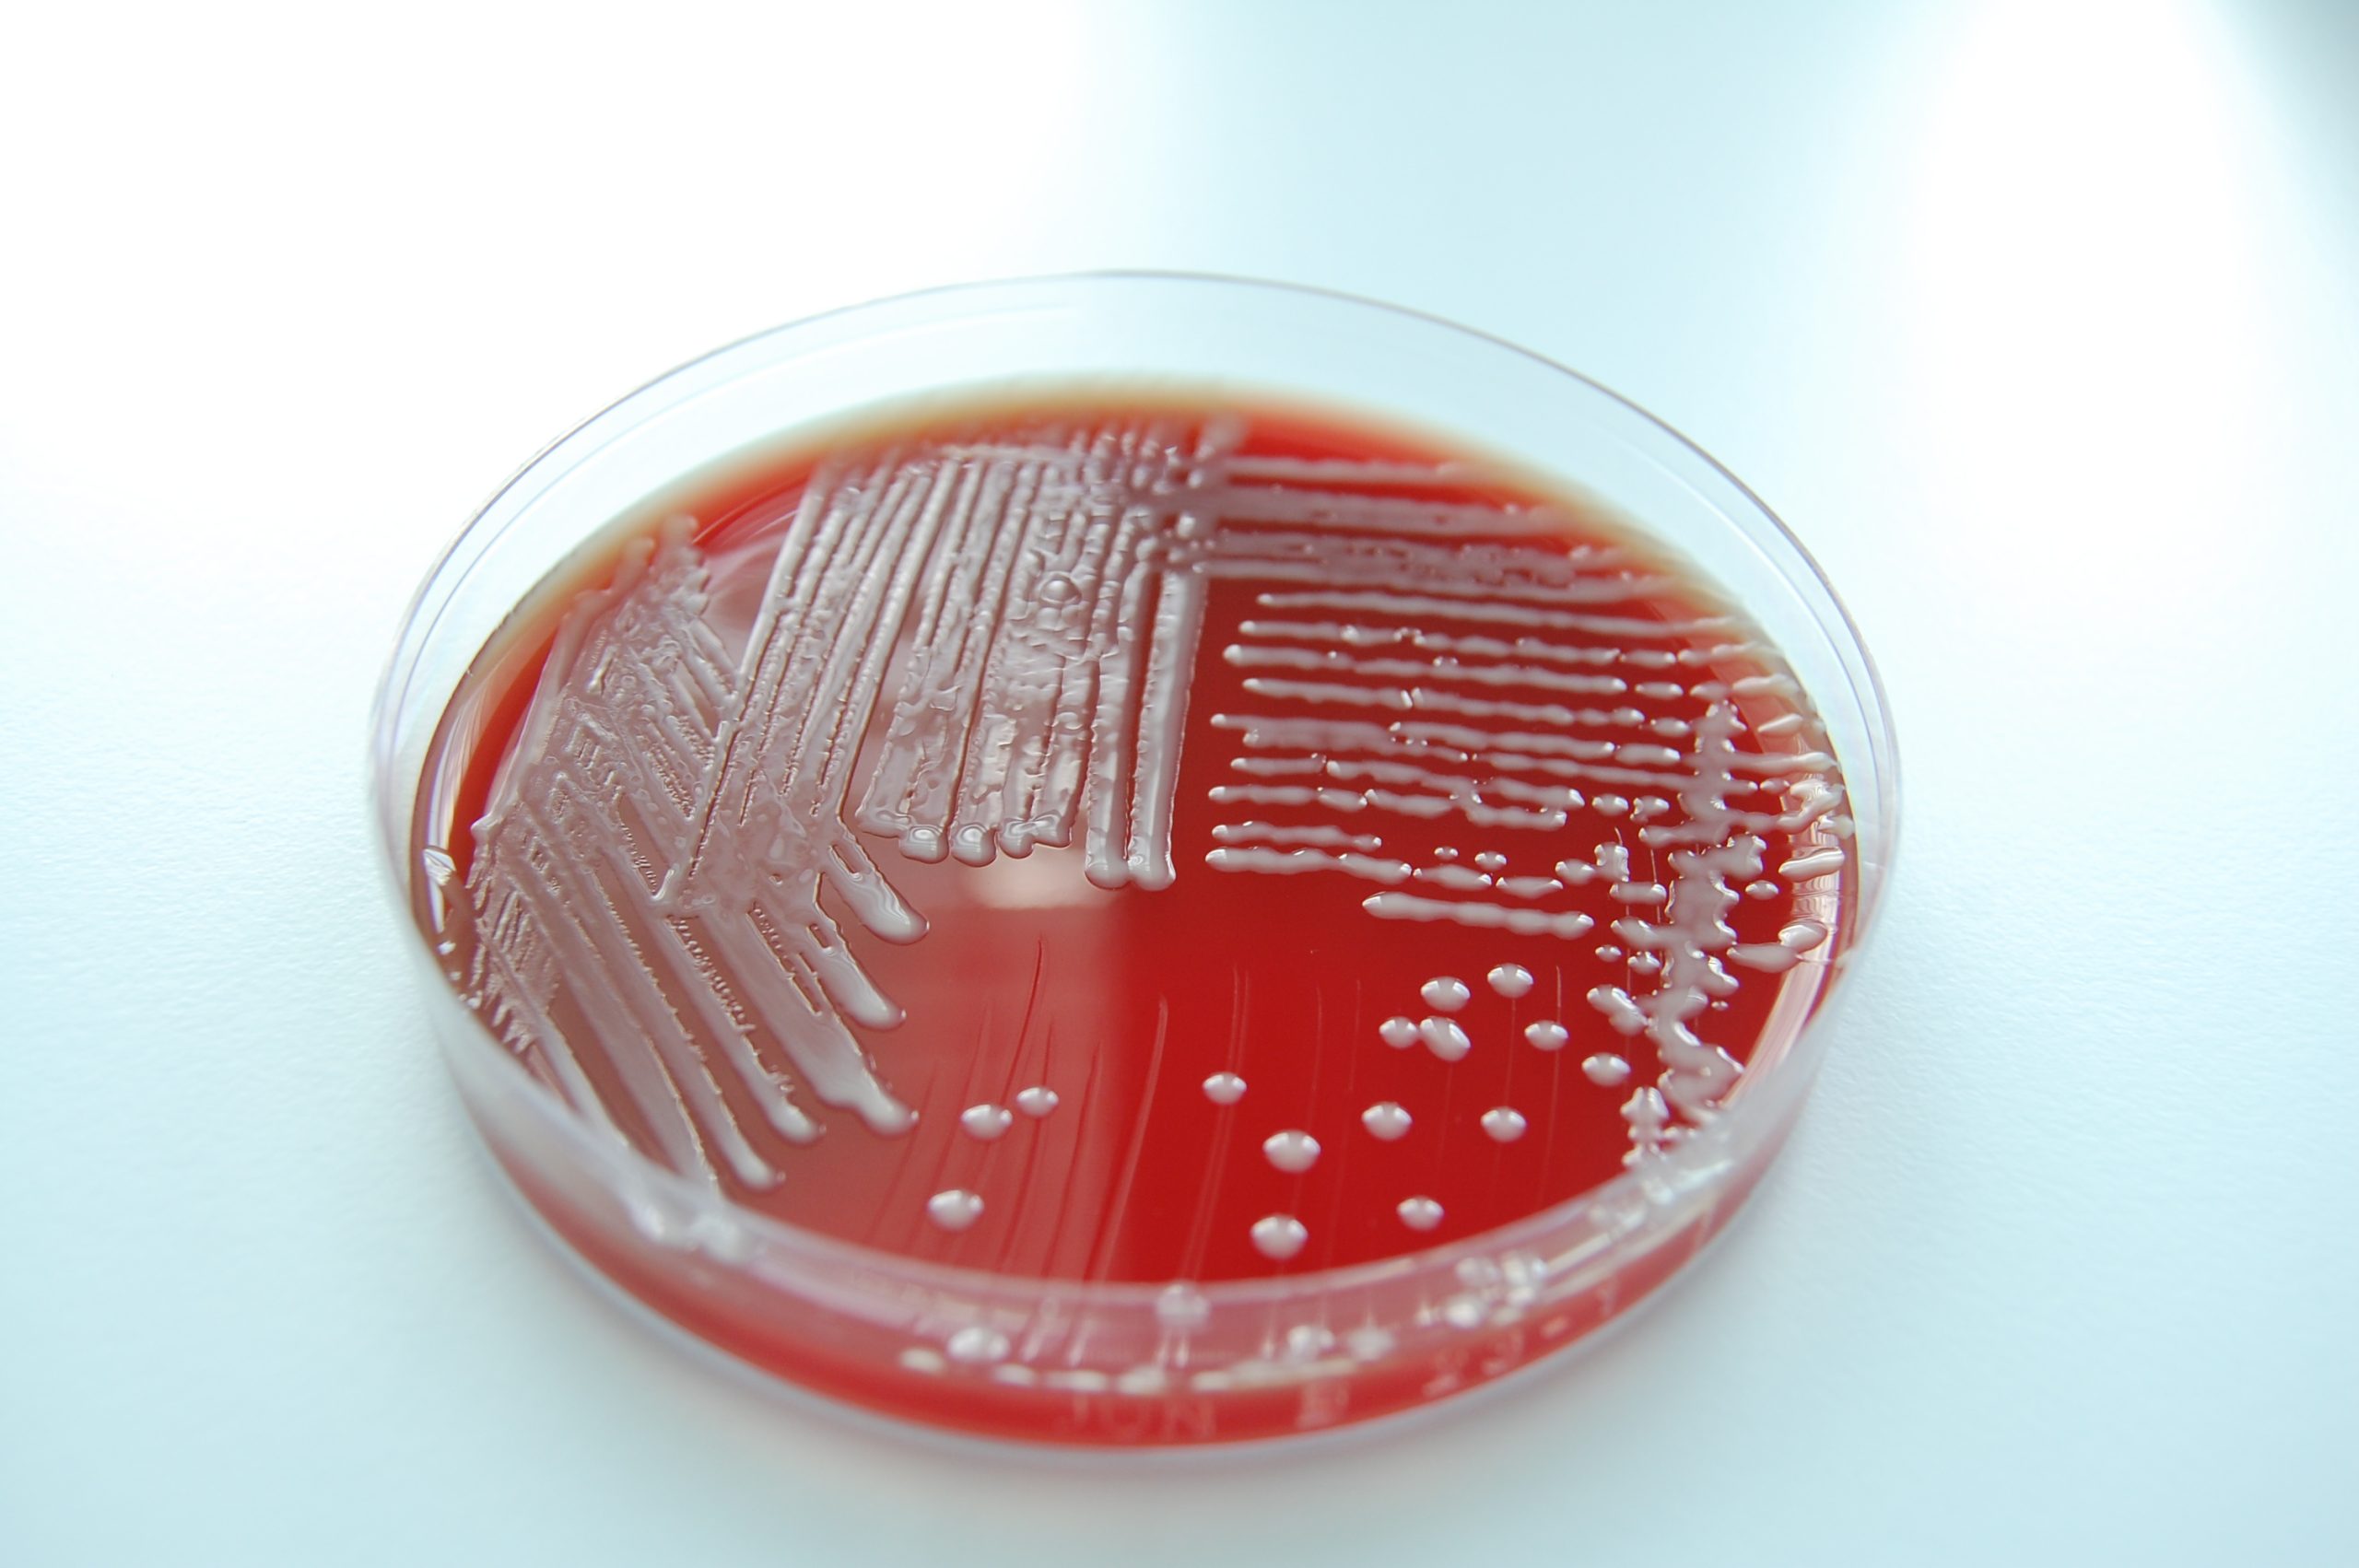

Mag. Silvia Stefan-Gromen
Ausgabe 02/2024
Um im Sinne des One-Health-Ansatzes die Entstehung und Verbreitung von Antibiotikaresistenzen massiv einzuschränken, hat Österreich basierend auf dem Tierarzneimittelgesetz (TAMG) und aufgrund von europäischen Verordnungen wie der Verordnung (EU) 2019/61 unterschiedliche gesetzlich vorgeschriebene Bestimmungen für Veterinärmediziner*innen eingeführt.
Das kürzlich beschlossene Tierarzneimittelgesetz zielt darauf ab, den Einsatz von Antibiotika in der Tiermedizin weiter einzuschränken bzw. die Abgabe mikrobieller Substanzen zielgerichteter zu gestalten.
Wie bereits in der Vetjournal-Ausgabe 12-2023 / 01-2024 berichtet ist die neue Regelung mit Jahresanfang 2024 in Kraft getreten – für praktizierende Tierärzt*innen bedeutet dies, dass bestimmte Antibiotika nur noch nach Erstellung eines Antibiogramms verordnet werden dürfen (siehe dazu auch das VETAK-Webinar zum neuen TAMG)2. Zu diesen Antibiotika zählen Fluorchinolone (z. B. Enrofloxacin) und Chephalosporine der 3. + 4. Generation. Hierbei handelt es sich um sehr potente antimikrobielle Wirkstoffe, die auch in der Humanmedizin eingesetzt werden. Von einem Antibiogramm kann im Rahmen der Diagnosestellung abgesehen werden, wenn vorhersehbar (Verantwortung TA) ist, dass
- die Probennahme mit der Gefahr einer mehr als geringfügigen Beeinträchtigung des Gesundheitszustands des zu behandelnden Tiers verbunden wäre, oder
- aufgrund einer vorangegangenen Behandlung mit antimikrobiell wirksamen Tierarzneimitteln bzw. antimikrobiell wirksamen Arzneimitteln mit verfälschten Ergebnissen zu rechnen wäre, oder
- der Erreger nicht mittels zellfreier künstlicher Medien kultiviert werden kann, oder
- für die Bestimmung der Empfindlichkeit des Erregers keine geeignete Methode zur Verfügung steht.
Bei einem Hintergrundgespräch mit dem Vetjournal erklärten die beiden Experten Dr. Michael Dünser, Leiter des AGES-Instituts für Veterinärmedizinische Untersuchungen Linz, und Dr. Eva Sodoma, Abteilungsleiterin am AGES-Institut für Veterinärmedizinische Untersuchungen Linz, weshalb das Antibiogramm in der täglichen Tierarztpraxis sehr sinnvoll ist: „Für die erfolgreiche Isolierung eines für ein Krankheitsgeschehen relevanten Erregers sind die Auswahl des geeigneten Untersuchungsmaterials und die sachgerechte Gewinnung der Proben von entscheidender Bedeutung. Gerade in der mikrobiologischen Diagnostik ist es wichtig, Proben von akut erkrankten und unbehandelten Tieren einzusenden, da durch vorherige Therapieversuche das Untersuchungsergebnis verfälscht werden kann. Ungekühlte und lange Probentransporte haben ebenfalls nachteilige Effekte. Erfahrenes und gut geschultes Personal sowie der Einsatz modernster und schneller Diagnostikverfahren sind die Erfolgsfaktoren für eine zuverlässige Diagnostik im veterinärmedizinischen Labor. Die Durchführung der Empfindlichkeitsprüfung setzt eine erfolgreiche Anzucht, Isolierung und eindeutige Identifizierung des bakteriellen Erregers voraus. Das Antibiogramm ist eine In-vitro-Testung von isolierten bakteriellen Erregern und dient der Vorauswahl von voraussichtlich in vivo wirksamen Antibiotika“, erklärt Dr. Dünser.
Dr. Sodoma fügt hinzu: „Eine umfassende Diagnostik verringert den unnötigen Einsatz von Antibiotika und die anschließende Empfindlichkeitstestung hilft dabei, das passende Antibiotikum auszuwählen. Der Grad der Empfindlichkeit eines Bakteriums gegenüber antimikrobiellen Wirkstoffen kann mittels unterschiedlicher Verfahren bestimmt werden. Eingesetzt werden das Bouillon-Mikrodilutionsverfahren zur Bestimmung der minimalen Hemmkonzentration, MHK, und das Agardiffusionsverfahren („Plättchentest“, Anm.). Methode der Wahl in der veterinärmedizinischen Labordiagnostik ist das Bouillon-Mikrodilutionsverfahren. Aufgrund der guten Standardisierbarkeit und Automatisierbarkeit dieses Verfahrens kann die Reproduzierbarkeit sowie eine Vergleichbarkeit zwischen verschiedenen Laboratorien sichergestellt werden.“
Dr. Dünser sagt abschließend: „Der zweckgerichtete Einsatz von antimikrobiellen Substanzen in der Tiermedizin leistet schlussendlich einen wesentlichen Beitrag, das Auftreten und die weitere Ausbreitung resistenter Mikroorganismen einzudämmen. Überdies kann durch den Einsatz geeigneter kommerzieller oder bestandsspezifischer Impfstoffe der Antibiotikaeinsatz zusätzlich reduziert respektive vermieden werden.“
Bullet Points
„Vom Erregernachweis zum Antibiogramm“
M. Dünser und E. Sodoma
-
Zunehmende Resistenzen pathogener Keime gegenüber antimikrobiellen Wirkstoffen bedeuten ein erhebliches Risiko für Mensch und Tier. Übermäßiger bzw. nicht zielgerichteter Einsatz von Antibiotika zählt zu den wichtigsten Ursachen für die Zunahme von Antibiotikaresistenzen in der Human- und Veterinärmedizin. Sorgfältiger und auf das therapeutisch notwendige Maß beschränkter Antibiotikaeinsatz sowie prophylaktische Maßnahmen zur Infektionsprävention sind unumgänglich, um das Risiko der Resistenzentwicklung zu minimieren. Gerade in der Prophylaxe können kommerzielle oder stallspezifische Vakzinen zusätzlich einen Beitrag zur Reduktion des Antibiotikaeinsatzes leisten.
-
Für die Isolierung eines für ein Krankheitsgeschehen ursächlichen Erregers bei klinisch erkrankten Tieren sind die Auswahl des geeigneten Untersuchungsmaterials und die sachgerechte Gewinnung der Proben sowie der Probentransport von entscheidender Bedeutung. Gerade bei der mikrobiologischen Diagnostik ist es wichtig, Proben von unbehandelten und akut erkrankten Tieren einzusenden, da durch vorherige Therapie das Untersuchungsergebnis verfälscht werden kann. Ungekühlte und lange Probentransporte haben ebenfalls nachteilige Effekte auf die Aussagekraft des Untersuchungsergebnisses.
-
Neben der Probengewinnung ist die Identifizierung von bakteriellen und viralen Infektionserregern mittels Kulturversuch und PCR essenziell. Qualifiziertes Personal und hochqualitative Analysetechniken sowie die Etablierung moderner und schneller Diagnostikverfahren stellen die Anforderungen und Erfolgsfaktoren für eine zuverlässige Diagnostik im veterinärmedizinischen Labor dar.
-
Die Durchführung der Empfindlichkeitsprüfung setzt eine erfolgreiche Anzucht, Isolierung und eindeutige Identifizierung des bakteriellen Erregers voraus. Das Antibiogramm ist eine In-vitro-Testung von isolierten bakteriellen Erregern und dient der Vorauswahl von voraussichtlich in vivo wirksamen Antibiotika.
-
Der Grad der Empfindlichkeit eines Bakteriums gegenüber antimikrobiellen Wirkstoffen kann mittels unterschiedlicher Verfahren bestimmt werden. Eingesetzt werden das Bouillon-Mikrodilutionsverfahren zur Bestimmung der minimalen Hemmkonzentration (MHK) und das Agardiffusionsverfahren (Plättchentest).
-
Methode der Wahl in der veterinärmedizinischen Labordiagnostik ist das Bouillon-Mikrodilutionsverfahren. Aufgrund der guten Standardisierbarkeit und Automatisierbarkeit dieses Verfahrens kann die Reproduzierbarkeit sowie eine Vergleichbarkeit der Resistenzdaten zwischen verschiedenen Laboratorien sichergestellt werden.
-
Eine umfassende Diagnostik verringert den unnötigen Einsatz von Antibiotika, da diese nur bei nachgewiesenen bakteriellen Infektionen einzusetzen sind.
-
Mithilfe der Empfindlichkeitstestung kann das geeignete Antibiotikum ausgewählt werden.
-
Daten aus einer standardisierten Empfindlichkeitsprüfung von tierpathogenen Bakterien können für nationale Resistenzmonitoring-
Programme verwendet werden. -
Der zweckgerichtete Einsatz von antimikrobiellen Substanzen in der Tiermedizin leistet einen wichtigen Beitrag, das Auftreten und die weitere Ausbreitung resistenter Mikroorganismen einzudämmen.
AGES Institut für Veterinärmedizinische Untersuchungen Linz
Wieningerstraße 8, 4020 Linz
vetmed.linz@ages.at